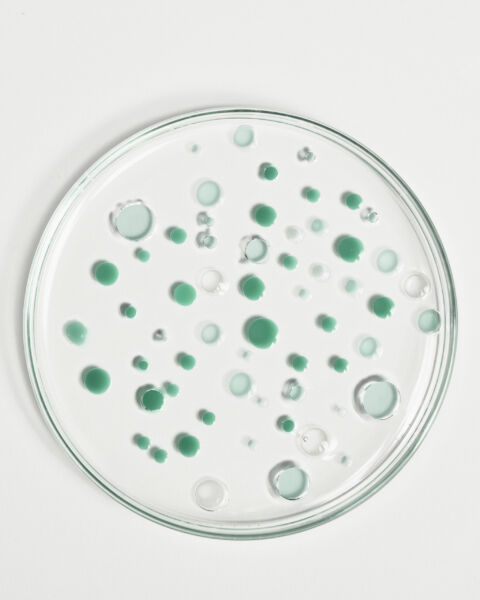

Une PURE obsession
Pour mettre en lumière les produits et les bienfaits de la gamme anti-imperfections de la jolie marque Patyka, nous avons conçu une série de vidéos et de photos pures, nettes, qui dévoilent la peau, les textures, les gestes
00:00
Sound
Off
On
Fullscreen

00:00
Sound
Off
On
Fullscreen

00:00
Sound
Off
On
Fullscreen

Crédits
Réalisatrice :
Chef Opérateur :
Electro :
Photographe :
Mannequin :
Chargées de production :
Directrice artistique :
Assistante DA et set design :
Make-up :
Monteuse :
Etalonneur :